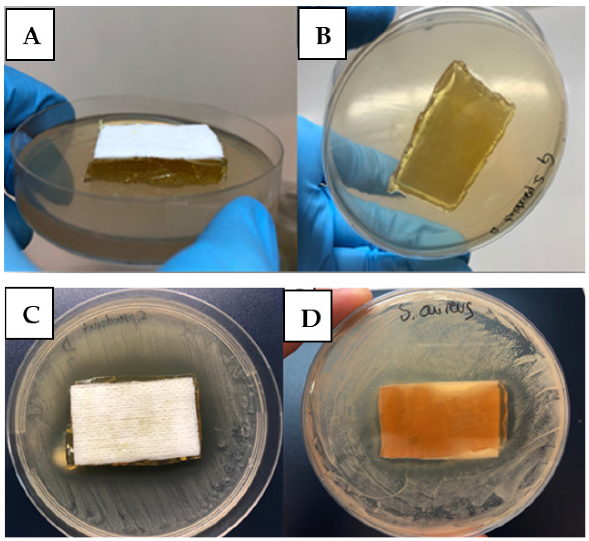

Antimicrobial and Antibiofilm Effect of 4,4′-Dihydroxy-azobenzene against Clinically Resistant Staphylococci
Abstract
1. Introduction
2. Results and Discussions
2.1. Determination of Bacterial Susceptibility towards DHAB
2.2. Evaluation of Oxidative Stress
2.3. Effect of DHAB on Biofilm Formation
2.4. Testing DHAB against Clinical Isolates of S. aureus
2.5. Designing a Therapeutic Utilization of DHAB for Dermatological Application in Veterinary Infections
3. Materials and Methods
3.1. Bacterial Strains and Culture Conditions
3.2. Determination of Bacterial Susceptibility towards Azo Compounds
3.2.1. Antimicrobial Disk Susceptibility Testing
3.2.2. Determination of MIC and MBC
3.3. Determination of ROS-Scavenging Enzymes
3.4. Determination of Damage to Membranes Based on Thiobarbituric Acid Reactive Substances (TBARS)
3.5. Effect of DHAB on Biofilm Formation
3.6. PFGE Electrophoresis
3.7. Statistical Analysis
4. Conclusions
Supplementary Materials
Author Contributions
Funding
Institutional Review Board Statement
Informed Consent Statement
Data Availability Statement
Acknowledgments
Conflicts of Interest
References
- Andersson, D.I.; Balaban, N.Q.; Baquero, F.; Courvalin, P.; Glaser, P.; Gophna, U.; Kishony, R.; Molin, S.; Tønjum, T. Antibiotic resistance: Turning evolutionary principles into clinical reality. FEMS Microbiol. Rev. 2020, 44, 171–188. [Google Scholar] [CrossRef] [PubMed]
- Rios, A.C.; Moutinho, C.G.; Pinto, F.C.; del Fiol, F.S.; Jozala, A.; Chaud, M.V.; Vila, M.M.D.C.; Teixeira, J.A.; Balcão, V.M. Alternatives to overcoming bacterial resistances: State-of-the-art. Microbiol. Res. 2016, 191, 51–80. [Google Scholar] [CrossRef] [PubMed]
- Ghosh, C.; Sarkar, P.; Issa, R.; Haldar, J. Alternatives to Conventional Antibiotics in the Era of Antimicrobial Resistance. Trends Microbiol. 2019, 27, 323–338. [Google Scholar] [CrossRef] [PubMed]
- Pfalzgraff, A.; Brandenburg, K.; Günther, W. Antimicrobial Peptides and Their Therapeutic Potential for Bacterial Skin Infections and Wounds. Front. Pharmacol. 2018, 9, 281. [Google Scholar] [CrossRef] [PubMed]
- Liao, S.; Zhang, Y.; Pan, X.; Zhu, F.; Jiang, C.; Liu, Q.; Cheng, Z.; Dai, G.; Wu, G.; Wang, L.; et al. Antibacterial activity and mechanism of silver nanoparticles against multidrug-resistant Pseudomonas aeruginosa. Int. J. Nanomed. 2019, 14, 1469–1487. [Google Scholar] [CrossRef] [PubMed]
- Al-Jumaili, A.; Alancherry, S.; Bazaka, K.; Jacob, M.V. Review on the Antimicrobial Properties of Carbon Nanostructures. Materials 2017, 10, 1066. [Google Scholar] [CrossRef]
- Vollaro, A.; Esposito, A.; Antonaki, E.; Iula, V.D.; D’Alonzo, D.; Guaragna, A.; De Gregorio, E. Steroid Derivatives as Potential Antimicrobial Agents against Staphylococcus aureus Planktonic Cells. Microorganisms 2020, 8, 468. [Google Scholar] [CrossRef]
- Karlowsky, J.A.; Nichol, K.; Zhanel, G.G. Telavancin: Mechanisms of Action, In Vitro Activity, and Mechanisms of Resistance. Clin. Infect. Dis. 2015, 61, S58–S68. [Google Scholar] [CrossRef]
- Walther, B.; Tedin, K.; Lübke-Becker, A. Multidrug-resistant opportunistic pathogens challenging veterinary infection control. Vet. Microbiol. 2017, 200, 71–78. [Google Scholar] [CrossRef]
- Kaspar, U.; von Lützau, A.; Schlattmann, A.; Roesler, U.; Köck, R.; Becker, K. Zoonotic multidrug-resistant microorganisms among small companion animals in Germany. PLoS ONE 2018, 13, e0208364. [Google Scholar] [CrossRef]
- Somayaji, R.; Priyantha, M.A.; Rubin, J.E.; Church, D. Human infections due to Staphylococcus pseudintermedius, an emerging zoonosis of canine origin: Report of 24 cases. Diagn. Microbiol. Infect. Dis. 2016, 85, 471–476. [Google Scholar] [CrossRef]
- Lozano, C.; Rezusta, A.; Ferrer, I.; Pérez-Laguna, V.; Zarazaga, M.; Ruiz-Ripa, L.; Revillo, M.J.; Torres, C. Staphylococcus pseudintermedius Human Infection Cases in Spain: Dog-to-Human Transmission. Vector Borne Zoonotic Dis. 2017, 17, 268–270. [Google Scholar] [CrossRef]
- Kmieciak, W.; Szewczyk, E.M. Are zoonotic Staphylococcus pseudintermedius strains a growing threat for humans? Folia Microbiol 2018, 63, 743–747. [Google Scholar] [CrossRef]
- Holmstrom, T.; David, L.A.; Cousso da Motta, C.; Hebert dos Santos, T.; da Silva Coelho, I.; de Mattos de Oliveira Coelho, S.; de Melo, D.A.; de Souza, M.M.S. Methicillin-resistant Staphylococcus pseudintermedius: An underestimated risk at pet clinic. Braz. J. Vet. Med. 2021, 42, e107420. [Google Scholar] [CrossRef]
- Abdullahi, I.N.; Fernández-Fernández, R.; Juárez-Fernández, G.; Martínez-Álvarez, S.; Eguizábal, P.; Zarazaga, M.; Lozano, C.; Torres, C. Wild Animals Are Reservoirs and Sentinels of Staphylococcus aureus and MRSA Clones: A Problem with “One Health” Concern. Antibiotics 2021, 10, 1556. [Google Scholar] [CrossRef]
- Alsantali, R.I.; Raja, Q.A.; Alzahrani, A.Y.A.; Sadiq, A.; Naeem, N.; Mughal, E.U.; Al-Rooqi, M.M.; el Guesmi, N.; Moussa, Z.; Ahmed, S.A. Miscellaneous azo dyes: A comprehensive review on recent advancements in biological and industrial applications. Dyes Pigm. 2022, 199, 110050. [Google Scholar] [CrossRef]
- Eltaboni, F.; Bader, N.; El-Kailany, R.; Elsharif, N.; Ahmida, A. Chemistry and Applications of Azo Dyes: A Comprehensive Review. J. Chem. Rew. 2022, 4, 313–330. [Google Scholar] [CrossRef]
- Wolfbeis, O.S. Materials for fluorescence-based optical chemical sensors. J. Mater. Chem. 2005, 15, 2657–2669. [Google Scholar] [CrossRef]
- Fan, W.-J.; Shi, H.; Tan, D.-Z.; Xu, Z.-N.; Yu, N.-K.; Zhao, J.-L. Design of novel phenanthrocarbazole dyes for efficient applications in dye-sensitized solar cells. Comput. Mater. Sci. 2018, 151, 34–40. [Google Scholar] [CrossRef]
- Ali, Y.; Abd Hamid, S.; Rashid, U. Biomedical Applications of Aromatic Azo Compounds. Med. Chem. 2018, 18, 1548–1558. [Google Scholar] [CrossRef]
- Samper, K.G.; Lorenzo, J.; Capdevila, M.; Palacios, O.; Bayón, P. Functionalized azobenzene platinum(II) complexes as putative anticancer compounds. J. Biol. Inorg. Chem. 2021, 26, 435–453. [Google Scholar] [CrossRef] [PubMed]
- Akhter, M.; Husain, A.M.; Azad, B.; Ajmal, M. Aroylpropionic acid based 2,5-disubstituted-1,3,4-oxadiazoles: Synthesis and their anti-inflamatory and analgesic activities. Eur. J. Med. Chem. 2009, 44, 2372–2378. [Google Scholar] [CrossRef] [PubMed]
- Hager, T. The Demon Under the Microscope: From Battlefield Hospitals to Nazi Labs, One Doctor’s Heroic Search for the World’s First Miracle Drug. In Harmony Books; Three Rivers Press: New York, NY, USA, 2006; ISBN 1-4000-8214-5. [Google Scholar]
- Ngaini, Z.; Mortadza, N.A. Synthesis of halogenated azo-aspirin analogues from natural product derivatives as the potential antibacterial agent. Nat. Prod. Res. 2018, 33, 3507–3514. [Google Scholar] [CrossRef] [PubMed]
- Piotto, S.; Concilio, S.; Sessa, L.; Diana, R.; Torrens, G.; Juan, C.; Caruso, U.; Iannelli, P. Synthesis and Antimicrobial Studies of New Antibacterial Azo-Compounds Active against Staphylococcus aureus and Listeria monocytogenes. Molecules 2017, 22, 1372. [Google Scholar] [CrossRef] [PubMed]
- Ashraf, J.; Mughal, E.U.; Murtaza, S.; Sadiq, A.; Tanoli, S.A.K.; Mumtaz, A.; Hameed, A.; Mohammed, K.K.; Ahmed, I.; Khalid, B.; et al. Design, Synthesis and Antibacterial Activities of New Azo-compounds: An Experimental and a Computational Approach. Lett. Drug Des. Discov. 2017, 14, 10. [Google Scholar] [CrossRef]
- Karipcin, F.; Kabalcilar, E. Spectroscopic and thermal studies on solid complexes of 4-(2-pyridylazo) resorcinol with some transition metals. Acta Chim. Slov. 2007, 54, 242–247. [Google Scholar]
- Kuruba, B.K.; Emmanuvel, L.; Sridhar, B.; Vasanthkumar, S. Unprecedented cyclization of a-diazo hydrazones upon NH functionalization: A Et3N base promoted one-step synthetic approach for the synthesis of N-amino-1,2,3-triazole derivatives from a-diazo hydrazone. Tetrahedron 2017, 73, 2674–2681. [Google Scholar] [CrossRef]
- Ronson, T.K.; Adams, H.; Ward, M.D. Bis-dentate ligands containing two N,O-chelating pyrazolyl-phenolate units: Double helical complexes with Co (II), Cu (II), and Zn (II). Inorg. Chim. Acta 2005, 358, 1943–1954. [Google Scholar] [CrossRef]
- Domagk, G. Ein Beitrag zur Chemotherapie der bakteriellen infektionen. Dtsch. Med. Wochenschr. 1935, 61, 250–253. [Google Scholar] [CrossRef]
- Chung, K.T. Azo dyes and human health: A review. J. Environ. Sci. Health C Environ. Carcinog. Ecotoxicol. Rev. 2016, 34, 233–261. [Google Scholar] [CrossRef]
- Misal, S.A.; Gawai, K.R. Azoreductase: A key player of xenobiotic metabolism. Bioresour. Bioprocess. 2018, 5, 17. [Google Scholar] [CrossRef]
- Kofie, W.; Dzidzoramengor, C.; Adosraku, R.K. Synthesis and evaluation of antimicrobial properties of azo dyes. Int. J. Pharm. Pharm. Sci. 2014, 7, 398–401. [Google Scholar]
- Piotto, S.; Concilio, S.; Sessa, L.; Porta, A.; Calabrese, E.C.; Zanfardino, A.; Varcamonti, M.; Iannelli, P. Small azobenzene derivatives active against bacteria and fungi. Eur. J. Med. Chem. 2013, 68, 178–184. [Google Scholar] [CrossRef]
- Concilio, S.; Sessa, L.; Petrone, A.M.; Porta, A.; Diana, R.; Iannelli, P.; Piotto, S. Structure Modification of an Active Azo-Compound as a Route to New Antimicrobial Compounds. Molecules 2017, 22, 875. [Google Scholar] [CrossRef]
- Rezaei-Seresht, E.; Salimi, A.; Mahdavi, B. Synthesis, antioxidant and antibacterial activity of azo dye-stilbene hybrid compounds. Pigm. Resin Technol. 2019, 48, 84–88. [Google Scholar] [CrossRef]
- Concilio, S.; Iannelli, P.; Sessa, L.; Olivieri, R.; Porta, A.; De Santis, F.; Pantani, R.; Piotto, S. Biodegradable antimicrobial films based on poly (lactic acid) matrices and active azo compounds. J. Appl. Polym. Sci. 2015, 132, 42357. [Google Scholar] [CrossRef]
- Sessa, L.; Concilio, S.; Iannelli, P.; De Santis, F.; Porta, A.; Piotto, S. Antimicrobial azobenzene compounds and their potential use in biomaterials. AIP Conf. Proc. 2016, 1727, 020018. [Google Scholar] [CrossRef]
- Amin, K.A.; Hameid, A.H.; Elsttar, A.H. Effect of food azo dyes tartrazine and carmoisine on biochemical parameters related to renal, hepatic function and oxidative stress biomarkers in young male rats. Food Chem. Toxicol. 2010, 48, 2994–2999. [Google Scholar] [CrossRef]
- Abe, F.R.; Gravato, C.; Soares, A.M.V.M.; de Oliveira, D.P. Biochemical approaches to assess oxidative stress induced by exposure to natural and synthetic dyes in early life stages in zebrafish. J. Toxicol. Environ. Health A 2017, 80, 1259–1268. [Google Scholar] [CrossRef]
- Jadhav, S.B.; Surwase, S.N.; Kalyani, D.C.; Gurav, R.G.; Jadhav, J.P. Biodecolorization of azo dye Remazol orange by Pseudomonas aeruginosa BCH and toxicity (oxidative stress) reduction in Allium cepa root cells. Appl. Biochem. Biotechnol. 2012, 168, 1319–1334. [Google Scholar] [CrossRef]
- Ben Mansour, H.; Corroler, D.; Barillier, D.; Ghedira, K.; Chekir, L.; Mosrati, R. Evaluation of genotoxicity and pro-oxidant effect of the azo dyes: Acids yellow 17, violet 7 and orange 52, and of their degradation products by Pseudomonas putida mt-2. Food Chem. Toxicol. 2007, 45, 1670–1677. [Google Scholar] [CrossRef] [PubMed]
- Ben Mansour, H.; Mosratim, R.; Corrolerm, D.; Ghediram, K.; Barillierm, D.; Chekir-Ghediram, L. Mutagenicity and genotoxicity of acid yellow 17 and its biodegradation products. Drug Chem. Toxicol. 2009, 32, 222–229. [Google Scholar] [CrossRef] [PubMed]
- Ben Mansour, H.; Barillier, D.; Corroler, D.; Ghedira, K.; Chekir-Ghedira, L.; Mosrati, R. In vitro study of DNA damage induced by acid orange 52 and its biodegradation derivatives. Environ. Toxicol. Chem. 2009, 28, 489–495. [Google Scholar] [CrossRef]
- Lee, A.; de Lencastre, H.; Garau, J.; Kluytmans, J.; Malhotra-Kumar, S.; Peschel, A.; Harbarth, S. Methicillin-resistant Staphylococcus aureus. Nat. Rev. Dis. Prim. 2018, 4, 18033. [Google Scholar] [CrossRef] [PubMed]
- Da Costa, P.M.; Loureiro, L.; Matos, A.J. Transfer of multidrug-resistant bacteria between intermingled ecological niches: The interface between humans, animals and the environment. Int. J. Environ. Res. Public Health 2013, 10, 278–294. [Google Scholar] [CrossRef] [PubMed]
- O’Neil, J. Zoonotic Infections from Common Household Pets. J. Nurse Pract. 2018, 14, 363–370. [Google Scholar] [CrossRef]
- Cox, L.A., Jr.; Ricci, P.F. Causal regulations vs. political will: Why human zoonotic infections increase despite precautionary bans on animal antibiotics. Environ. Int. 2008, 34, 459–475. [Google Scholar] [CrossRef]
- Shin, B.; Park, W. Zoonotic Diseases and Phytochemical Medicines for Microbial Infections in Veterinary Science: Current State and Future Perspective. Front. Vet. Sci. 2018, 5, 166. [Google Scholar] [CrossRef]
- Garg, S.K.; Tripathi, M. Microbial Strategies for Discoloration and Detoxification of Azo Dyes from Textile Effluents. Res. J. Microbiol. 2017, 12, 1–19. [Google Scholar] [CrossRef]
- Singh, P.K.; Singh, R.M. Bio-removal of Azo Dyes: A Review. Int. J. Appl. Sci. Biotechnol. 2017, 5, 108–126. [Google Scholar] [CrossRef]
- EUCAST. European Committee on Antimicrobial Susceptibility Testing Routine and Extended Internal Quality Control for MIC Determination and Disk Diffusion as Recommended by EUCAST. Version 12.0, Valid from 2022-01-01. 2022, p. 9. Available online: https://www.eucast.org/clinical_breakpoints (accessed on 7 December 2022).
- Kaur, S.; Kaur, A. Variability in antioxidant/detoxification enzymes of Labeo rohita exposed to an azo dye, acid black (AB). Comparative Biochemistry and physiology. Toxicol. Pharmcol. CBP 2014, 167, 108–116. [Google Scholar] [CrossRef]
- Pan, H.; Feng, J.; Cerniglia, C.E.; Chen, H. Effects of Orange II and Sudan III azo dyes and their metabolites on Staphylococcus aureus. J. Ind. Microbiol. Biotechnol. 2011, 38, 1729–1738. [Google Scholar] [CrossRef]
- Singh, V.K.; Moskovitz, J. Multiple methionine sulfoxide reductase genes in Staphylococcus aureus: Expression of activity and roles in tolerance to oxidative stress. Microbiol. Read. 2003, 149 Pt 10, 2739–2747. [Google Scholar] [CrossRef]
- Bedekar, P.A.; Saratale, R.G.; Saratale, G.D.; Govindwar, S.P. Oxidative stress response in dye degrading bacterium Lysinibacillus sp. RGS exposed to Reactive Orange 16, degradation of RO16 and evaluation of toxicity. Environ. Sci. Pollut. Res. Int. 2014, 21, 11075–11085. [Google Scholar] [CrossRef]
- Behera, N.; Arakha, M.; Priyadarshinee, M.; Pattanayak, B.S.; Soren, S.; Jha, S.; Mallick, B.C. Oxidative stress generated at nickel oxide nanoparticle interface results in bacterial membrane damage leading to cell death. RSC Adv. 2019, 9, 24888–24894. [Google Scholar] [CrossRef]
- Pan, H.; Feng, J.; He, G.X.; Cerniglia, C.E.; Chen, H. Evaluation of impact of exposure of Sudan azo dyes and their metabolites on human intestinal bacteria. Anaerobe 2012, 18, 445–453. [Google Scholar] [CrossRef]
- MacKenzie, K.D.; Palmer, M.B.; Köster, W.L.; White, A.P. Examining the Link between Biofilm Formation and the Ability of Pathogenic Salmonella Strains to Colonize Multiple Host Species. Front. Vet. Sci. 2017, 4, 138. [Google Scholar] [CrossRef]
- Cattelan, N.; Jennings-Gee, J.; Dubey, P.; Yantorno, O.M.; Deora, R. Hyperbiofilm Formation by Bordetella pertussis Strains Correlates with Enhanced Virulence Traits. Infect. Inmun. 2017, 85, e00373-17. [Google Scholar] [CrossRef]
- Singh, A.; Walker, M.; Rousseau, J.; Weese, J.S. Characterization of the biofilm forming ability of Staphylococcus pseudintermedius from dogs. BMC Vet. Res. 2013, 9, 93. [Google Scholar] [CrossRef]
- Arima, S.; Ochi, H.; Mitsuhashi, M.; Kibe, R.; Takahashi, K.; Kataoka, Y. Staphylococcus pseudintermedius biofilms secrete factors that induce inflammatory reactions in vitro. Lett. Appl. Microbiol. 2018, 67, 214–219. [Google Scholar] [CrossRef]
- Sabino, H.A.C.; Valera, F.C.P.; Santos, D.V.; Fantucci, M.Z.; Titoneli, C.C.; Martínez, R.; Anselmo-Lima, W.T.; Tamashiro, E. Biofilm and Planktonic Antibiotic Resistance in Patients With Acute Exacerbation of Chronic Rhinosinusitis. Front. Cell Infect. Microbiol. 2022, 11, 813076. [Google Scholar] [CrossRef] [PubMed]
- Dutt, Y.; Dhiman, R.; Singh, T.; Vibhuti, A.; Gupta, A.; Pandey, R.P.; Raj, V.S.; Chang, C.-M.; Priyadarshini, A. The Association between Biofilm Formation and Antimicrobial Resistance with Possible Ingenious Bio-Remedial Approaches. Antibiotics 2022, 11, 930. [Google Scholar] [CrossRef] [PubMed]
- Chakraborty, S.P.; Mahapatra, S.K.; Roy, S. Biochemical characters and antibiotic susceptibility of Staphylococcus aureus isolates. Asian Pac. J. Trop. Biomed. 2011, 1, 212–216. [Google Scholar] [CrossRef] [PubMed]
- Zou, W.; Cerniglia, C.E.; Chen, H. Azoreductase in Staphylococcus aureus. Curr. Protoc. Toxicol. 2009, 41, 4.28.1–4.28.9. [Google Scholar] [CrossRef] [PubMed]
- Chen, H. Recent Advances in Azo Dye Degrading Enzyme Research. Curr. Prot. Pept. Sci. 2006, 7, 101–111. [Google Scholar] [CrossRef]
- Smith, A.W. Biofilms and antibiotic therapy: Is there a role for combating bacterial resistance by the use of novel drug delivery systems? Adv. Drug Deliv. Rev. 2005, 57, 1539–1550. [Google Scholar] [CrossRef]
- Hillier, A.; Lloyd, D.H.; Weese, J.S.; Blondeau, J.M.; Boothe, D.; Breitschwerdt, E.; Guardabassi, L.; Papich, M.G.; Rankin, S.; Turnidge, J.D.; et al. Guidelines for the diagnosis and antimicrobial therapy of canine superficial bacterial folliculitis (Antimicrobial Guidelines Working Group of the International Society for Companion Animal Infectious Diseases). Vet. Dermatol. 2014, 25, e142–e163. [Google Scholar] [CrossRef]
- Costa, F.; Sousa, D.M.; Parreira, P.; Lamghari, M.; Gomes, P.; Martins, M.C.L. N-acetylcysteine-functionalized coating avoids bacterial adhesion and biofilm formation. Sci. Rep. 2017, 7, 17374. [Google Scholar] [CrossRef]
- Eroshenko, D.; Polyudova, T.; Korobov, V. N-acetylcysteine inhibits growth, adhesion and biofilm formation of Gram-positive skin pathogens. Microb. Pathog. 2017, 105, 145–152. [Google Scholar] [CrossRef]
- Ayare, N.N.; Ramugade, S.H.; Sekar, N. Photostable coumarin containing azo dyes with multifunctional property. Dye. Pigm. 2019, 163, 692–699. [Google Scholar] [CrossRef]
- Myers, J.; Hennessey, M.; Arnold, J.-C.; McCubbin, K.D.; Lembo, T.; Mateus, A.; Kitutu, F.E.; Samanta, I.; Hutchinson, E.; Davis, A.; et al. Crossover-Use of Human Antibiotics in Livestock in Agricultural Communities: A Qualitative Cross-Country Comparison between Uganda, Tanzania and India. Antibiotics 2022, 11, 1342. [Google Scholar] [CrossRef]
- CLSI (Clinical Laboratory Standard Institute). M02 Performance Standards for Antimicrobial Disk Susceptibility Test, 11th ed.; Clinical and Laboratory Standards Institute: Wayne, PA, USA, 2018. [Google Scholar]
- CLSI (Clinical Laboratory Standard Institute). M07 Methods for Dilution Antimicrobial Susceptibility Test for Bacteria That Grow Aerobically, 11th ed.; Clinical and Laboratory Standards Institute: Wayne, PA, USA, 2018. [Google Scholar]
- Pine, L.; Hoffman, P.S.; Malcom, G.B.; Benson, R.F.; Keen, M.G. Determination of catalase, peroxidase, and superoxide dismutase within the genus Legionella. J. Clin. Microbiol. 1984, 20, 421–429. [Google Scholar] [CrossRef]
- Chance, B.; Maehly, A.C. Assay of Catalases and Peroxidases. Methods Enzymol. 1955, 2, 764–775. [Google Scholar] [CrossRef]
- Beyer, W.F.; Fridovich, I. Assaying for Superoxide dismutase activity: Some large consequences of minor changes in conditions. Anal. Biochem. 1987, 161, 559–566. [Google Scholar] [CrossRef]
- Bradford, M.M. A rapid and sensitive method for the quantitation of microgram quantities of protein utilizing the principle of protein-dye binding. Anal. Biochem. 1976, 7, 248–254. [Google Scholar] [CrossRef]
- Ong, K.S.; Cheow, Y.L.; Lee, S.M. The role of reactive oxygen species in the antimicrobial activity of pyochelin. J. Adv. Res. 2017, 8, 393–398. [Google Scholar] [CrossRef]
- O’Toole, G.A. Microtiter dish biofilm formation assay. J. Vis. Exp. 2011, 47, 2437. [Google Scholar] [CrossRef]
- Tenover, F.C.; Arbeit, R.D.; Goering, R.V.; Mickelsen, P.A.; Murray, B.E.; Persing, D.H.; Swaminathan, B. Interpreting chromosomal DNA restriction patterns produced by pulsed-field gel electrophoresis: Criteria for bacterial strain typing. J. Clin. Microbiol. 1995, 33, 2233–2239. [Google Scholar] [CrossRef]

| Bacteria | Parameter | |
|---|---|---|
| Staphylococcus aureus ATCC 29213 | MIC | 64 mg L−1 |
| MBC | 256 mg L−1 | |
| Staphylococcus pseudintermedius LMG 22219 | MIC | 32 mg L−1 |
| MBC | 64 mg L−1 | |
| Name of the Compound | R1 | R2 | R3 | R4 | R5 | MIC (mg mL−1) | Reference | |
|---|---|---|---|---|---|---|---|---|
| E. coli | S. aureus | |||||||
| 4-((4-Hydroxyphenyl)4iazinyl) benzene-1,3-diol | OH | OH | H | OH | H | >128 | >128 | Piotto et al., 2017 [25] |
| 4-(p-Tolyldiazenyl) benzene-1,3-diol | CH3 | OH | H | OH | H | >32 | >32 | Piotto et al., 2017 [25] |
| 4-((4-Methoxyphenyl)4iazinyl) benzene-1,3-diol | OCH3 | OH | H | OH | H | >128 | 16 | Piotto et al., 2017 [25] |
| 4′-Hydroxyazobenzene | OH | H | H | H | H | N.D. | 25 | Concilio et al., 2017 [35] |
| 4′-Hydroxy-4- methoxyazobenzene | OH | H | H | CH3 | H | N.D. | 25 | Concilio et al., 2017 [35] |
| 4′-Hydroxy-4- Methylazobenzene | OH | H | H | OCH3 | H | N.D. | 20 | Concilio et al., 2017 [35] |
| DHAB | OH | H | H | OH | H | >512 | 64 | This work |
| Antimicrobial Agent | MIC (mg L−1) |
|---|---|
| Ciprofloxacin | 0.25 |
| Gentamicin | 0.25–0.5 |
| Erythromycin | 0.5 |
| Vancomicin | 1 |
| Fosfomycin | 1–2 |
| Amikacin | 2 |
| Cefoxitin | 2 |
| Chloramphenicol | 4–8 |
| Nitrofurantoin | 16 |
| DHAB | 64 |
| Strain | Enzyme | Activity (mU mg−1 Protein) | ||
|---|---|---|---|---|
| Control | DHAB at MIC | DHAB at MBC | ||
| S. pseudintermedius LMG 22219 | Catalase | 0.75 ± 0.12 (a) | 0.38 ± 0.06 (b) | 0.66 ± 0.04 (a) |
| Total Peroxidase | 26 ± 2 (a) | 4.0 ± 1.0 (b) | 21.0 ± 6.0 (a) | |
| Superoxide dismutase | 11.09 ± 1.33 (a) | 12.60 ± 1.50 (a) | 23.75 ± 1.93 (b) | |
| S. aureus ATCC 29213 | Catalase | 0.74 ± 0.14 (a) | 0.44 ± 0.07 (b) | 0.84 ± 0.06 (a) |
| Total Peroxidase | 25.0 ± 6.0 (a) | 2.6 ± 0.4 (b) | 70.0 ± 14.0 (c) | |
| Superoxide dismutase | 4.90 ± 0.50 (a) | 3.94 ± 0.30 (a) | 5.09 ± 0.52 (a) | |
| Sample Identification | Clinical Sample | CLON | Determinant | CMI (mg L−1) | CMB (mg L−1) |
|---|---|---|---|---|---|
| SA1 | Blood | ST30 | MRSA | 64 | 256 |
| SA2 | Swab | ST30 DR | MSSA (DAPTO R) | 64 | 256 |
| SA3 | Respiratory tract | ST22 | MRSA | 64 | 256 |
| SA4 | Swab | ST5 | MSSA (DAPTO R) | 64 | 256 |
| SA5 | Injury swab | ST146 | MRSA | 64 | 256 |
| SA6 | Swab | ST125 | MRSA | 64 | 256 |
| SA7 | Nasal smear | ST15 | MRSA | 64 | 256 |
| SA8 | Nasal smear | ST72 | MRSA | 64 | 256 |
| SA9 | Swab | ST8 | MRSA | 256 | >512 |
| SA10 | Respiratory tract | ST1 | MRSA | 256 | >512 |
| ATCC 29213 | MSSA | 64 | 256 |
Publisher’s Note: MDPI stays neutral with regard to jurisdictional claims in published maps and institutional affiliations. |
© 2022 by the authors. Licensee MDPI, Basel, Switzerland. This article is an open access article distributed under the terms and conditions of the Creative Commons Attribution (CC BY) license (https://creativecommons.org/licenses/by/4.0/).
Share and Cite
Pérez-Aranda, M.; Pajuelo, E.; Navarro-Torre, S.; Pérez-Palacios, P.; Begines, B.; Rodríguez-Llorente, I.D.; Torres, Y.; Alcudia, A. Antimicrobial and Antibiofilm Effect of 4,4′-Dihydroxy-azobenzene against Clinically Resistant Staphylococci. Antibiotics 2022, 11, 1800. https://doi.org/10.3390/antibiotics11121800
Pérez-Aranda M, Pajuelo E, Navarro-Torre S, Pérez-Palacios P, Begines B, Rodríguez-Llorente ID, Torres Y, Alcudia A. Antimicrobial and Antibiofilm Effect of 4,4′-Dihydroxy-azobenzene against Clinically Resistant Staphylococci. Antibiotics. 2022; 11(12):1800. https://doi.org/10.3390/antibiotics11121800
Chicago/Turabian StylePérez-Aranda, María, Eloísa Pajuelo, Salvadora Navarro-Torre, Patricia Pérez-Palacios, Belén Begines, Ignacio D. Rodríguez-Llorente, Yadir Torres, and Ana Alcudia. 2022. "Antimicrobial and Antibiofilm Effect of 4,4′-Dihydroxy-azobenzene against Clinically Resistant Staphylococci" Antibiotics 11, no. 12: 1800. https://doi.org/10.3390/antibiotics11121800
APA StylePérez-Aranda, M., Pajuelo, E., Navarro-Torre, S., Pérez-Palacios, P., Begines, B., Rodríguez-Llorente, I. D., Torres, Y., & Alcudia, A. (2022). Antimicrobial and Antibiofilm Effect of 4,4′-Dihydroxy-azobenzene against Clinically Resistant Staphylococci. Antibiotics, 11(12), 1800. https://doi.org/10.3390/antibiotics11121800

